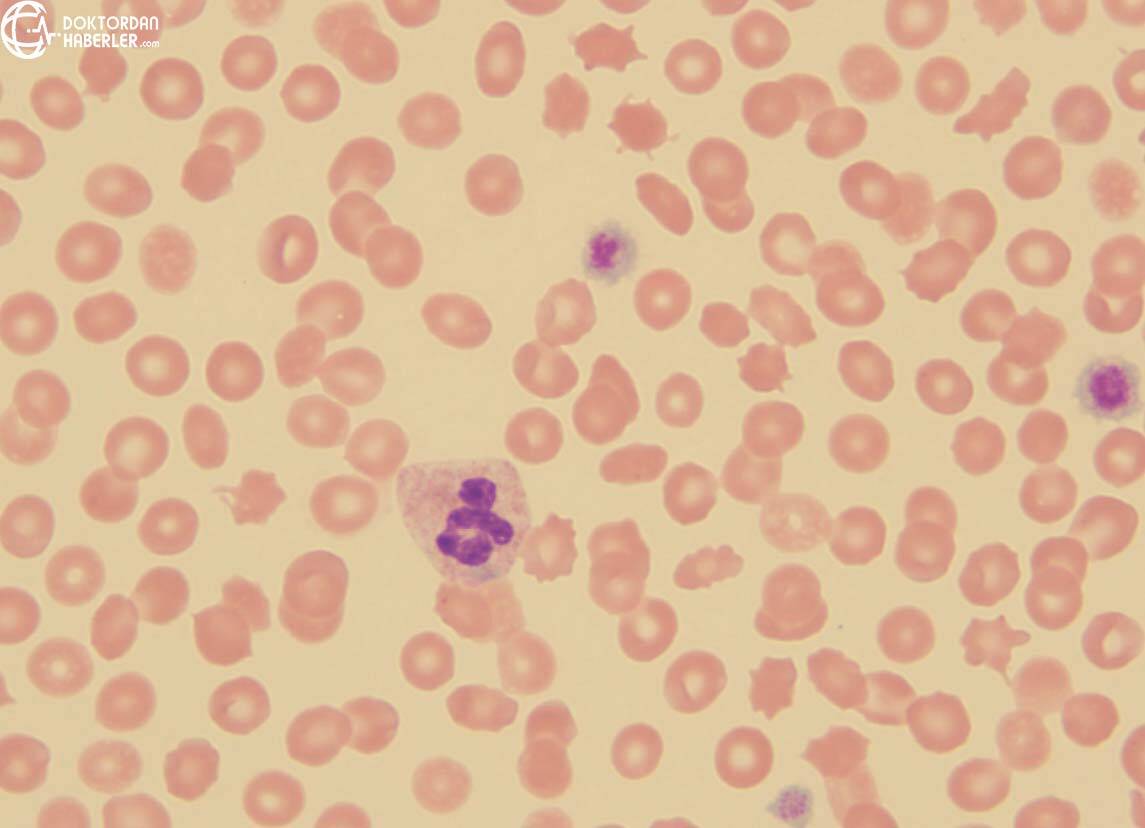
bernard soulier sendromu tedavisi

HGB Nedir? Kan Tahlili Hemoglobin Rehberi
Yazar: Dr. Erhan Yavuz
Hemoglobin, temel olarak kırmızı kan hücrelerinde yer alan vücudumuzda oksijenin dolaşımına yardımcı olan karmaşık protein yapıda bir maddedir. Hayati fonksiyonların sorunsuz bir şekilde sürdürülebilmesi için …